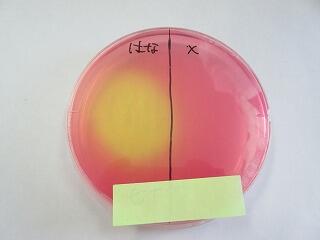

食品工学科ブログ
食品工学科2年 企業視察研修
こんにちは 食品工学科2年ブログ係です。
宮崎市島之内にある、いちごポタジェ株式会社さんの農園の視察に行きました。
いちごポタジェさんは宮崎市内に2つの農園があり、いちごやバナナ、ライチ、
コショウ、カカオ、マンゴーなどを栽培されています。
今回はバナナ、ライチ、コショウの農園を見学させていただきました。


バナナは、木でなく葉がたまねぎのように重なったものであること、
バナナの花は「バナナハート」といい食べられること、
バナナは茎まで食べられることなどさまざまなことを学ぶことができました。
コショウはホワイトペッパー、ブラックペッパー、レッドペッパーなど
いろいろな種類があり、処理の仕方で呼び名が変わることや
非常に貴重なコショウの花を見学することができました。

ライチの収穫期間の短さや、ビニールハウスの外と中の気温の差、
生のライチと加熱処理されたライチの見分け方などいろいろなことを
教えていただきました。

今回の研修を通して、普段見ることの出来ない農業の現場を見学でき、
さまざまなことを質問して自分たちの課題研究へのヒントを得ることが
できました。この経験を無駄にせず充実した課題研究を進めていきたいです。
食品工学科2年 製菓講習会(和菓子)
こんにちは!食品工学科2年ブログ係です。
先日、マナビヤ宮崎アカデミーの鷺坂先生にお越しいただき、
練り切りの作り方を教えていただきました。

練り切りは白あんと求肥などを入れ、木ベラでしっかりと練りながら作られたものです。
色粉などで色をつけ、季節の鳥や花などを写しとって作られる芸術的な和菓子です。
今回はウグイス、うさぎ、菊、ミモザの作り方を教えていただきました。
鷺坂先生から作り方を教わった後、班ごとに分かれて練り切りと中に包むあん(赤あん)を分割し、
練り切りが白っぽくなるまで練ります。


自分の作りたいものをイメージして作っていきます!
みんな上手に作ることが出来ました。
出来上がった和菓子は、抹茶と一緒にいただきました!
抹茶を初めて飲んだ人たちは、抹茶の苦みと和菓子の甘さが合うことに驚いていました。
鷺坂先生からは、和菓子製造以外にも、
「高校生として今身につけておかなければならないこと」など
多くのことを教えていただくことができました。
普段の実習では学ぶことが出来ない和菓子を
自分の手で作り上げることができて充実した実習になりました。
食品工学科1年 パウンドケーキ製造
こんにちは 食品工学科1年 広報係です。
今回は科目「総合実習」で
パウンドケーキを製造しました。
粉をふるい、材料を混ぜていきます。卵とバターがしっかり混ざるように(乳化)
交代で混ぜました。
型に生地を入れた後オーブンに入れます。
15分後、表面に切れ目を入れます。
165℃で45分焼いたら完成です!
切れ目を入れた部分がきれいになりました。
外は茶色でサクサクで、中はしっとりして美味しかったです。
初めてのパウンドケーキ実習は楽しくできました!
食品工学科1年 ミカンの実験
こんにちは。食品工学科一年の広報係です。
みなさんは、ミカンの缶詰のミカンの薄皮をどのように取り除いているか知っていますか?
今回は、ミカンの薄皮を取り除く実験をしました。
はじめに、外の皮(外果皮)をむいて一房ごとに分けます。
外果皮は熱湯に30秒ほどつけると、むきやすくなります。
ミカンを入れたビーカーに薄い濃度の塩酸溶液を入れ、40℃に温めます。
水洗いし、薄い濃度の水酸化ナトリウム水溶液を入れ、40℃で温めます。
左が元のミカン、右のざる入っているのが、薄皮がとれた
ミカンです。缶詰の中身のように、きれいに薄皮がとれました!
「塩酸」と「水酸化ナトリウム」を使っていると聞くと、
「体に良くないのでは?」と思う人もいるかと思いますが、
溶液の濃度が低いことと、流水で完全に取り除くので、体への影響はありません。
身近な食品ですが、製造方法は考えたことがなかったので知るきっかけになりました。
食品の「なぜ?」が解決できる実験でした。
食品工学科1年 製菓講習会
こんにちは。食品工学科一年の広報係です。
パティスリーエスサンクの末永様を講師にお招きし、
製菓講習会を行いました。
今回はラングドシャを製造しました。
「ラングドシャ」とはフランス語で「猫の舌」という意味だそうです。
細長い形と表面がざらざらした感じが似ていることが由来です。
学校では、マドレーヌやパウンドケーキを製造していますが、
ラングドシャも同じ材料・配合割合で作ると聞き、驚きました!
バターと卵白を混ぜ合わせるのに苦労しましたが、末永さんに指導していただきながら
どの班も上手に作ることが出来ました!
出来上がったラングドシャにガナッシュ(生クリームとホワイトチョコレートを混ぜたもの)を
挟み、完成です!
試食してみると、サクサクの生地に濃厚なガナッシュがマッチしておいしかったです!
チョコレート細工もしていただき、プロの技を間近で見ることができました。
初めての製菓講習会で最初は緊張しましたが、楽しい実習になりました。
今日学んだことを、今後の実習に活かしていきたいと思います。
食品工学科2年 微生物実験②
こんにちは 食品工学科2年 広報係です
今回は、培地(微生物の栄養源になるもの)を使って、私たちの体の中に常にいる菌を検出し、調べました。
鼻・口・口内炎・喉を綿棒で拭い培地に塗布しました。
口からの検出 鼻からの検出
【実験の結果】
もともと赤い培地だったのが、黄色く変色していました。
黄色くなった理由は、食中毒の原因でもある黄色ブドウ球菌の働きによるものです。
黄色く変色した菌の集落(集まり)をコロニーといいます。
黄色ブドウ球菌は常在細菌の一種で、体内や皮膚に生息しています。
常在細菌は黄色ブドウ球菌以外にも、乳酸菌や虫歯(ミュータンス菌)などがあります。
今の季節は食中毒が増えてくるので、こまめに手を洗うようにして実習に取り組んでいます!!
食中毒の対策として、本校の実習では手袋の着用や、こまめな消毒を心がけています!!
食品工学科2年 東洋食品工業短期大学 出前授業
こんにちは!食品工学科2年生広報係です。
6月21日に東洋食品工業短期大学の出前授業がありました!!

これは缶詰の蓋を締める仕組みを学んでいるところです。二重巻締(にじゅうまきしめ)という方法で蓋を締めています。
これは、ペットボトルの蓋を締めているところ(左)とアルミ缶の蓋を機械を使って締めているところ(右)です。

普段食べたり飲んだりする食品を安全においしく提供するために、どんな包装がされているのか、
どのように密封しているのか、身を持って知ることができ、とてもよい機会になりました。

いろいろなことが学べて視野が広がり、包装のことについて深く考えることができてよかったです!!
食品工学科 広報係です!
私たちは食品工学科の2年生と3年生です。
食品工学科の授業内容や活動を知ってもらうために、
私たち広報係が、ブログで発信していくことになりました。
「農業と情報」という授業でSNSの機能について学んだので、
みなさんに伝わりやすい内容になるように頑張ります!

食品工学科2年 【微生物実験】
こんにちは!私たちは食品工学科2年広報係です。
今日は実験の様子を紹介します!
みなさんは普段生活しているこの空間に微生物は存在していると思いますか❔
私たちは今回自分たちの「手」と「身の回り」の微生物について採取・培養・観察を行いました。
~観察の様子~
身の回りに潜む菌(中央の写真)
顕微鏡観察の準備 麹菌 机の上で採取した菌
これからも実習や実験について伝えていきたいと思います!
(担当職員より)
食品工学科では2年生から「食品微生物」という授業が始まります。
それと同時に、微生物に関する実験を少人数(12人程度)で3週間に1回行います。
この実験をとおして、微生物の種類や働きなどを学んでいきます。
食品工学科1年【総合実習】
食品工学科の「総合実習」では、1クラスが3班に分かれて実習・実験を行います。
今回は「クッキー製造」「酸乳飲料培養」「グルテンの抽出」を行いました。
①実習:クッキー製造
原材料を混ぜて、しぼり袋で天板に出します。
オーブンで15分焼いたら出来上がりです。



器具洗い、実習机・床の清掃も時間内に行います。

②実習:酸乳飲料培養
宮崎農業高校では「ユース」という酸乳飲料を製造しています。
今日は脱脂粉乳と水を殺菌して冷やしてから乳酸菌を加え、培養を行いました。
大きなタンクで2日間培養します。

次回の製造(瓶詰)に向けて、瓶洗いも行います。
③実験:グルテンの抽出
小麦粉は含まれているタンパク質の量によって、「強力粉」「中力粉」「薄力粉」などに分類されます。
今回は、タンパク質である『グルテン』を抽出して、小麦粉の違いを比較しました。
小麦粉に水を混ぜてよくこねます。
しばらく水に浸して、デンプンを洗い流します。

残ったものがタンパク質の『グルテン』です。
このように食品工学科では実験・実習を通して、食品について学んでいきます。
これからも実習や授業風景をブログに掲載していきたいと思います。




実習の様子






「スイーツプロジェクト」!本校食品工学科の生徒の作品が最優秀賞に選ばれています。
表彰式の様子などが一般社団法人みやPEC推進機構で紹介されています。ご覧下さい。(←クリック)